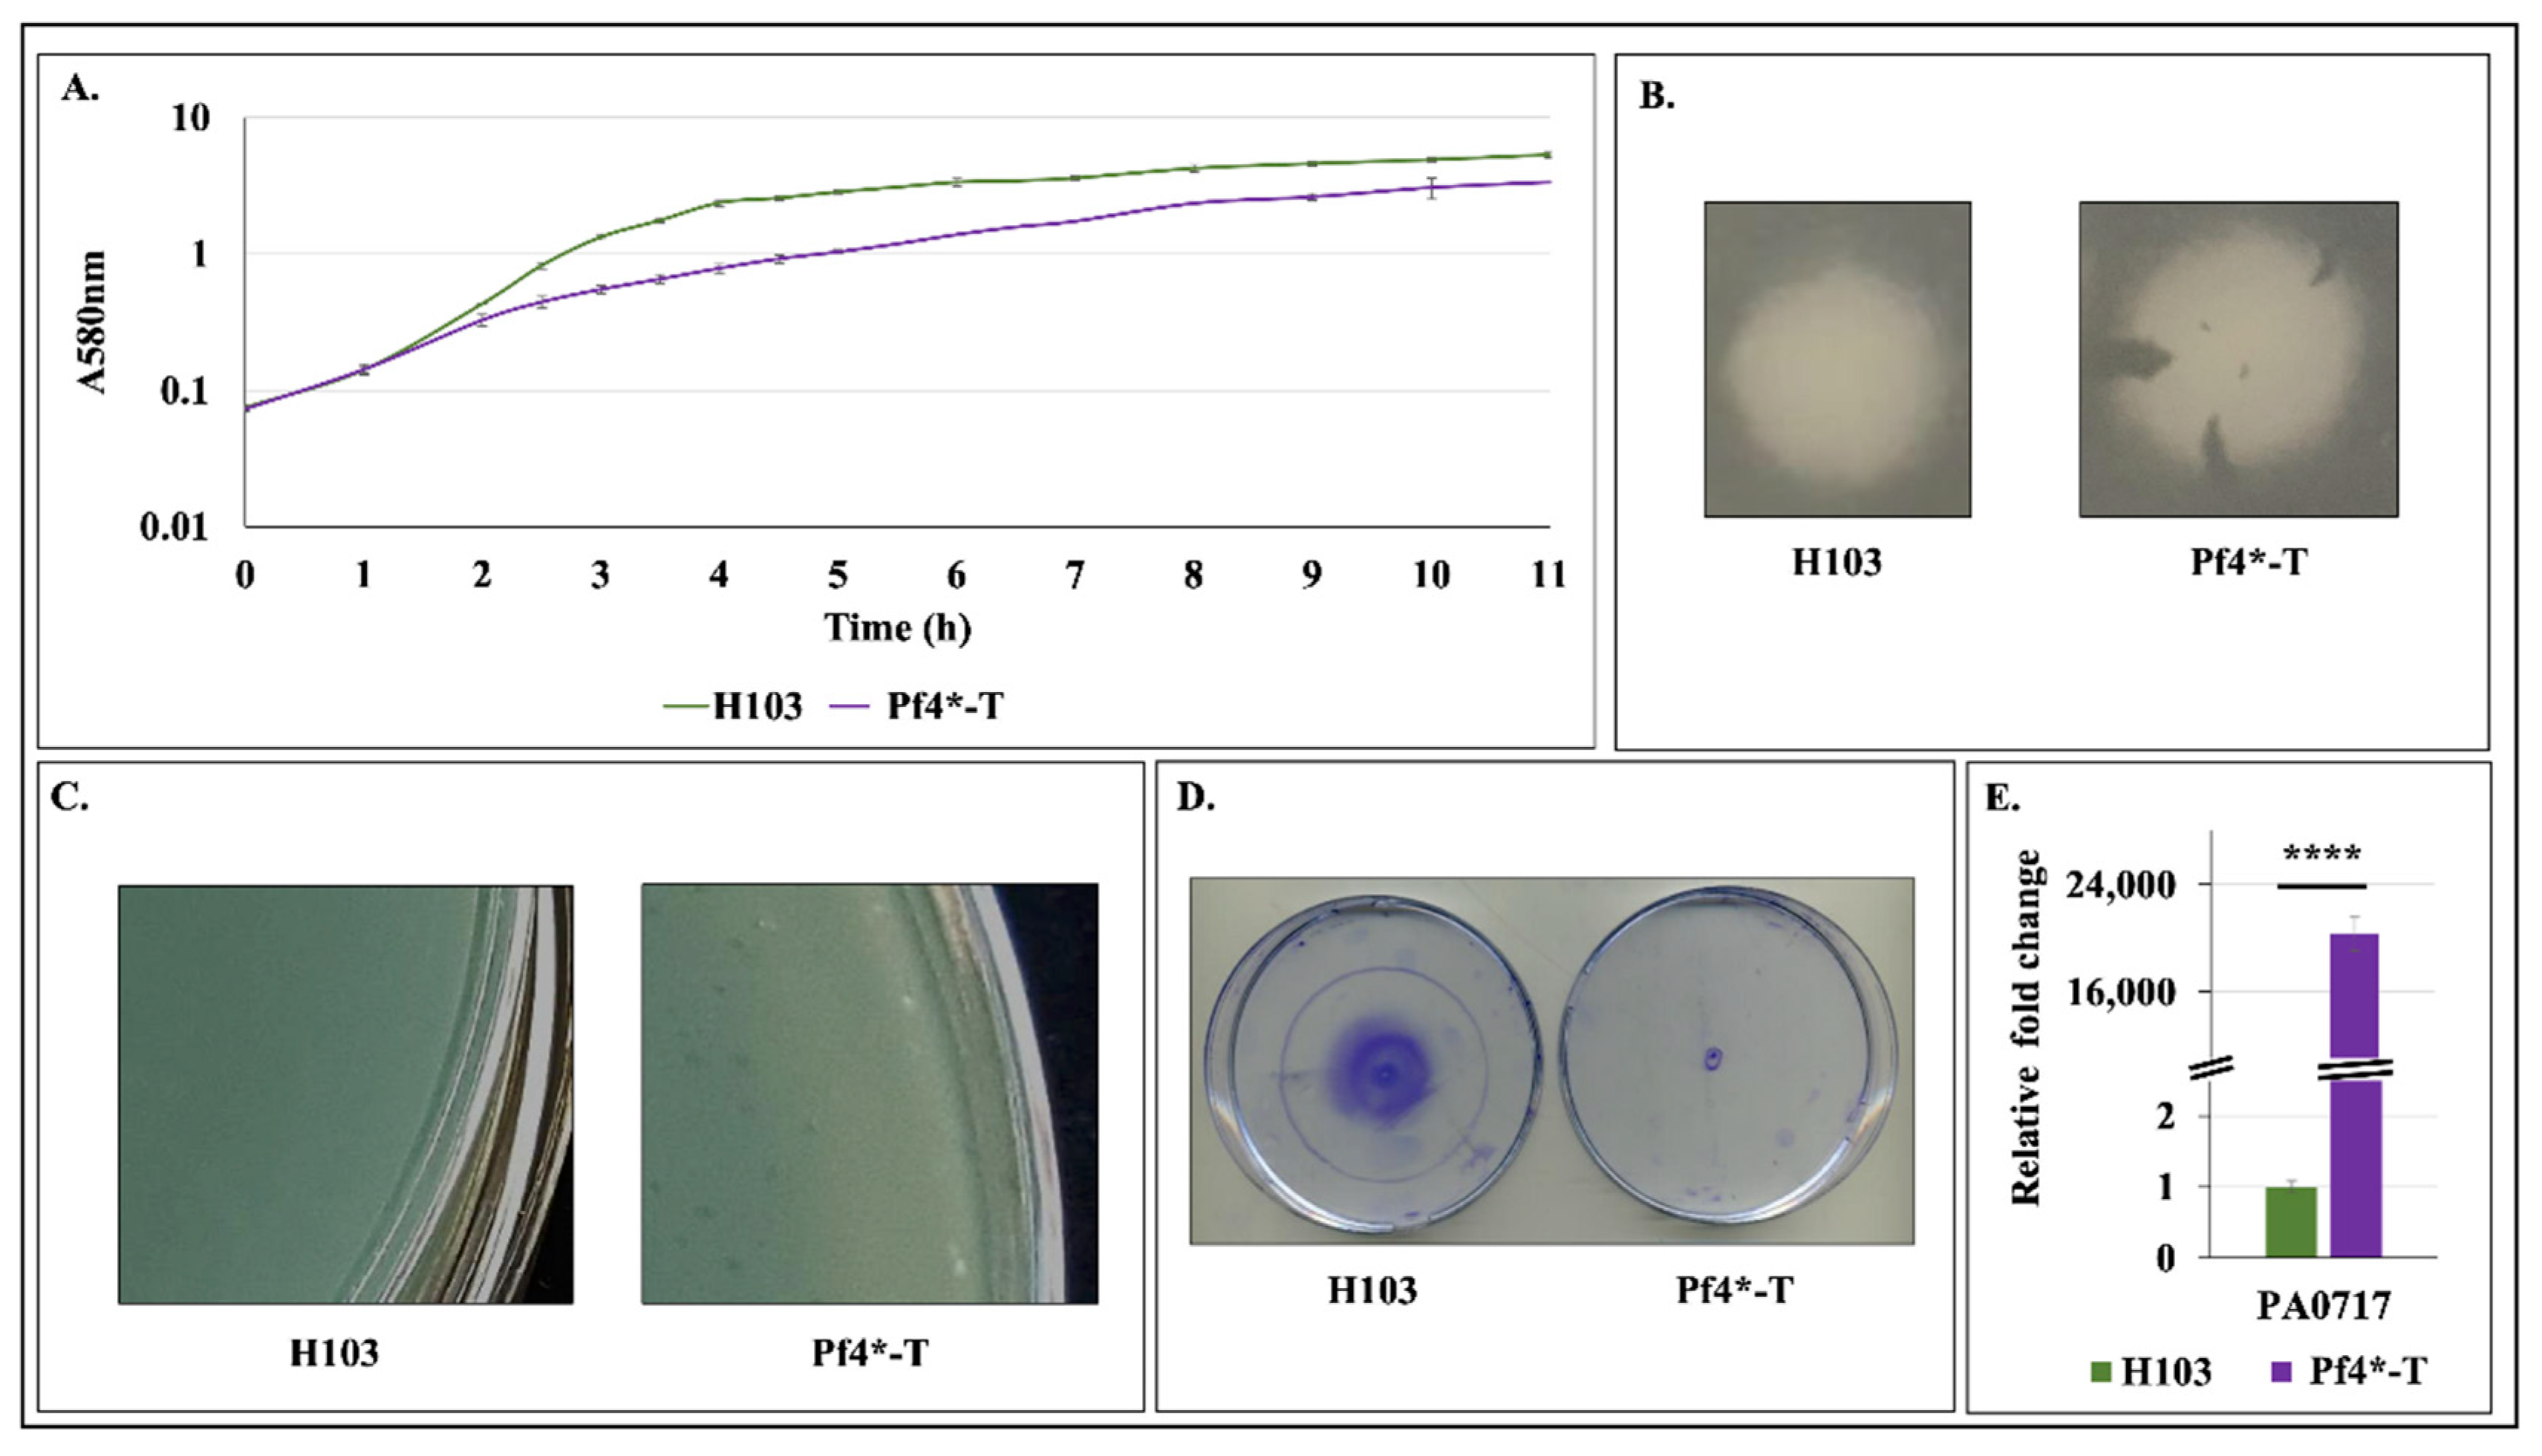
Microorganisms 08 01700 g002 Microorganisms 08 01700 g002

Activation of the Cell Wall Stress Response in Pseudomonas aeruginosa Infected by a Pf4 Phage Variant
Abstract
1. Introduction
2. Materials and Methods
2.1. Pf4 Phage Variant Production
2.2. Bacterial Strains, Media, and Growth Conditions
2.3. Numeration of Pf4* Phages by Double Agar Overlay Plaque Assay
2.4. Quantitative Reverse-Transcription Real-Time PCR (RT-qPCR) Analyses
2.5. Twitching Motility
2.6. Biofilm Culture
2.7. Confocal Laser Scanning Microscopy (CLSM)
2.8. Transmission Electron Microscopy (TEM)
2.9. c-di-GMP Quantification
2.10. Membrane Fluidity Assays by Fluorescence Anisotropy
2.11. Pf4 Prophage Region Sequencing
2.12. Promoter Research
2.13. Statistical Analyses
3. Results and Discussion
3.1. Production of Superinfective Pf4 Phages Variant under Planktonic Culture Conditions
3.2. H103 Infection by the Pf4 Variant
3.3. Pf4 Variant Infection Affects Biofilm Architecture and Cell Morphology
3.4. Increased Matrix-Encoding Genes Expression and c-di-GMP Production in Response to Pf4 Variant Infection
3.5. Pf4 Phage Variant Infection Triggers a SigX-Mediated Cell Envelope Stress Response
3.6. Pf4 Phage Variant Infection Induces P. aeruginosa Membrane Fluidity Alteration
3.7. Pf4 Phage Variant Infection Triggers an AlgU-Mediated Cell Envelope Stress Response
3.8. Does the CESR Mediated by SigX and AlgU Rely on Pf4 Phage Variant Infection?
4. Concluding Remarks
Supplementary Materials
Author Contributions
Funding
Acknowledgments
Conflicts of Interest
References
- Goldberg, J.B. Pseudomonas: Global bacteria. Trends Microbiol. 2000, 8, 55–57. [Google Scholar] [CrossRef] [PubMed]
- Spiers, A.J.; Buckling, A.; Rainey, P.B. The causes of Pseudomonas diversity. Microbiology 2000, 146, 2345–2350. [Google Scholar] [CrossRef]
- Lyczak, J.B.; Cannon, C.L.; Pier, G.B. Establishment of Pseudomonas aeruginosa infection: Lessons from a versatile opportunist. Microbes Infect. 2000, 2, 1051–1060. [Google Scholar]
- Wei, Q.; Ma, L.Z. Biofilm matrix and its regulation in Pseudomonas aeruginosa. Int. J. Mol. Sci. 2013, 14, 20983–21005. [Google Scholar] [CrossRef] [PubMed]
- Hoiby, N.; Ciofu, O.; Bjarnsholt, T. Pseudomonas aeruginosa biofilms in cystic fibrosis. Future Microbiol. 2010, 5, 1663–1674. [Google Scholar] [CrossRef] [PubMed]
- Ryder, C.; Byrd, M.; Wozniak, D.J. Role of polysaccharides in Pseudomonas aeruginosa biofilm development. Curr. Opin. Microbiol. 2007, 10, 644–648. [Google Scholar] [CrossRef] [PubMed]
- Mai-Prochnow, A.; Hui, J.G.; Kjelleberg, S.; Rakonjac, J.; McDougald, D.; Rice, S.A. Big things in small packages: The genetics of filamentous phage and effects on fitness of their host. FEMS Microbiol. Rev. 2015, 39, 465–487. [Google Scholar] [CrossRef] [PubMed]
- Roux, S.; Krupovic, M.; Daly, R.A.; Borges, A.L.; Nayfach, S.; Schulz, F.; Sharrar, A.; Carnevali, P.B.M.; Cheng, J.-F.; Ivanova, N.N.; et al. Cryptic inoviruses revealed as pervasive in bacteria and archaea across Earth’s biomes. Nat. Microbiol. 2019, 4, 1895–1906. [Google Scholar] [CrossRef]
- Mooij, M.J.; Drenkard, E.; Llamas, M.A.; Vandenbroucke-Grauls, C.M.; Savelkoul, P.H.; Ausubel, F.M.; Bitter, W. Characterization of the integrated filamentous phage Pf5 and its involvement in small-colony formation. Microbiology 2007, 153, 1790–1798. [Google Scholar] [CrossRef]
- Rakonjac, J.; Bennett, N.J.; Spagnuolo, J.; Gagic, D.; Russel, M. Filamentous bacteriophage: Biology, phage display and nanotechnology applications. Curr. Issues Mol. Biol. 2011, 13, 51–76. [Google Scholar]
- Holland, S.J.; Sanz, C.; Perham, R.N. Identification and specificity of pilus adsorption proteins of filamentous bacteriophages infecting Pseudomonas aeruginosa. Virology 2006, 345, 540–548. [Google Scholar] [CrossRef] [PubMed]
- Castang, S.; Dove, S.L. Basis for the essentiality of H-NS family members in Pseudomonas aeruginosa. J. Bacteriol. 2012, 194, 5101–5109. [Google Scholar] [CrossRef] [PubMed]
- McElroy, K.E.; Hui, J.G.; Woo, J.K.; Luk, A.W.; Webb, J.S.; Kjelleberg, S.; Rice, S.A.; Thomas, T. Strain-specific parallel evolution drives short-term diversification during Pseudomonas aeruginosa biofilm formation. Proc. Natl. Acad. Sci. USA 2014, 111, E1419–E1427. [Google Scholar] [CrossRef] [PubMed]
- Webb, J.S.; Lau, M.; Kjelleberg, S. Bacteriophage and phenotypic variation in Pseudomonas aeruginosa biofilm development. J. Bacteriol. 2004, 186, 8066–8073. [Google Scholar] [CrossRef]
- Kirov, S.M.; Webb, J.S.; Che, Y.O.; Reid, D.W.; Woo, J.K.; Rice, S.A.; Kjelleberg, S. Biofilm differentiation and dispersal in mucoid Pseudomonas aeruginosa isolates from patients with cystic fibrosis. Microbiology 2007, 153, 3264–3274. [Google Scholar] [CrossRef]
- Platt, M.D.; Schurr, M.J.; Sauer, K.; Vazquez, G.; Kukavica-Ibrulj, I.; Potvin, E.; Levesque, R.C.; Fedynak, A.; Brinkman, F.S.L.; Schurr, J.; et al. Proteomic, microarray, and signature-tagged mutagenesis analyses of anaerobic Pseudomonas aeruginosa at pH 6.5, likely representing chronic, late-stage cystic fibrosis airway conditions. J. Bacteriol. 2008, 190, 2739–2758. [Google Scholar] [CrossRef]
- Secor, P.R.; Jennings, L.K.; Michaels, L.A.; Sweere, J.M.; Singh, P.K.; Parks, W.C.; Bollyky, P.L. Biofilm assembly becomes crystal clear—filamentous bacteriophage organize the Pseudomonas aeruginosa biofilm matrix into a liquid crystal. Microb. Cell 2015, 3, 49–52. [Google Scholar] [CrossRef]
- Secor, P.R.; Sweere, J.M.; Michaels, L.A.; Malkovskiy, A.V.; Lazzareschi, D.; Katznelson, E.; Rajadas, J.; Birnbaum, M.E.; Arrigoni, A.; Braun, K.R.; et al. Filamentous Bacteriophage Promote Biofilm Assembly and Function. Cell Host Microbe 2015, 18, 549–559. [Google Scholar] [CrossRef]
- Rice, S.A.; Tan, C.H.; Mikkelsen, P.J.; Kung, V.; Woo, J.; Tay, M.; Hauser, A.; McDougald, D.; Webb, J.S.; Kjelleberg, S. The biofilm life cycle and virulence of Pseudomonas aeruginosa are dependent on a filamentous prophage. ISME J. 2009, 3, 271–282. [Google Scholar] [CrossRef]
- Whiteley, M.; Bangera, M.G.; Bumgarner, R.E.; Parsek, M.R.; Teitzel, G.M.; Lory, S.; Greenberg, E.P. Gene expression in Pseudomonas aeruginosa biofilms. Nature 2001, 413, 860–864. [Google Scholar] [CrossRef]
- Stanley, N.R.; Britton, R.A.; Grossman, A.D.; Lazazzera, B.A. Identification of catabolite repression as a physiological regulator of biofilm formation by Bacillus subtilis by use of DNA microarrays. J. Bacteriol. 2003, 185, 1951–1957. [Google Scholar] [CrossRef] [PubMed]
- Domka, J.; Lee, J.; Bansal, T.; Wood, T.K. Temporal gene-expression in Escherichia coli K-12 biofilms. Environ. Microbiol. 2007, 9, 332–346. [Google Scholar] [CrossRef] [PubMed]
- Guilbaud, M.; Bruzaud, J.; Bouffartigues, E.; Orange, N.; Guillot, A.; Aubert-Frambourg, A.; Monnet, V.; Herry, J.-M.; Chevalier, S.; Bellon-Fontaine, M.-N. Proteomic Response of Pseudomonas aeruginosa PAO1 Adhering to Solid Surfaces. Front. Microbiol. 2017, 8, 1465. [Google Scholar] [CrossRef] [PubMed]
- Hui, J.G.; Mai-Prochnow, A.; Kjelleberg, S.; McDougald, D.; Rice, S.A. Environmental cues and genes involved in establishment of the superinfective Pf4 phage of Pseudomonas aeruginosa. Front. Microbiol. 2014, 5, 654. [Google Scholar] [CrossRef]
- Baraquet, C.; Harwood, C.S. Use of Nonradiochemical DNAse Footprinting to Analyze c-di-GMP Modulation of DNA-Binding Proteins. Methods Mol. Biol. 2017, 1657, 303–315. [Google Scholar] [CrossRef] [PubMed]
- Li, Y.; Liu, X.; Tang, K.; Wang, P.; Zeng, Z.; Guo, Y.; Wang, X. Excisionase in Pf filamentous prophage controls lysis-lysogeny decision-making in Pseudomonas aeruginosa. Mol. Microbiol. 2019, 111, 495–513. [Google Scholar] [CrossRef] [PubMed]
- Wei, Q.; Minh, P.N.; Dotsch, A.; Hildebrand, F.; Panmanee, W.; Elfarash, A.; Schulz, S.; Plaisance, S.; Charlier, D.; Hassett, D.; et al. Global regulation of gene expression by OxyR in an important human opportunistic pathogen. Nucleic Acids Res. 2012, 40, 4320–4333. [Google Scholar] [CrossRef]
- Baraquet, C.; Murakami, K.; Parsek, M.R.; Harwood, C.S. The FleQ protein from Pseudomonas aeruginosa functions as both a repressor and an activator to control gene expression from the pel operon promoter in response to c-di-GMP. Nucleic Acids Res. 2012, 40, 7207–7218. [Google Scholar] [CrossRef]
- Chevalier, S.; Bouffartigues, E.; Bazire, A.; Tahrioui, A.; Duchesne, R.; Tortuel, D.; Maillot, O.; Clamens, T.; Orange, N.; Feuilloley, M.; et al. Extracytoplasmic function sigma factors in Pseudomonas aeruginosa. Biochim. Biophys. Acta Gene Regul. Mech. 2019, 1862, 706–721. [Google Scholar] [CrossRef]
- Wood, L.F.; Leech, A.J.; Ohman, D.E. Cell wall-inhibitory antibiotics activate the alginate biosynthesis operon in Pseudomonas aeruginosa: Roles of sigma (AlgT) and the AlgW and Prc proteases. Mol. Microbiol. 2006, 62, 412–426. [Google Scholar] [CrossRef]
- Wood, L.F.; Ohman, D.E. Use of cell wall stress to characterize sigma 22 (AlgT/U) activation by regulated proteolysis and its regulon in Pseudomonas aeruginosa. Mol. Microbiol. 2009, 72, 183–201. [Google Scholar] [CrossRef]
- Aspedon, A.; Palmer, K.; Whiteley, M. Microarray analysis of the osmotic stress response in Pseudomonas aeruginosa. J. Bacteriol. 2006, 188, 2721–2725. [Google Scholar] [CrossRef]
- Bouffartigues, E.; Moscoso, J.A.; Duchesne, R.; Rosay, T.; Fito-Boncompte, L.; Gicquel, G.; Maillot, O.; Bénard, M.; Bazire, A.; Brenner-Weiss, G.; et al. The absence of the Pseudomonas aeruginosa OprF protein leads to increased biofilm formation through variation in c-di-GMP level. Front. Microbiol. 2015, 6, 630. [Google Scholar] [CrossRef]
- Firoved, A.M.; Boucher, J.C.; Deretic, V. Global genomic analysis of AlgU (sigma(E))-dependent promoters (sigmulon) in Pseudomonas aeruginosa and implications for inflammatory processes in cystic fibrosis. J. Bacteriol. 2002, 184, 1057–1064. [Google Scholar] [CrossRef]
- Bouffartigues, E.; Gicquel, G.; Bazire, A.; Bains, M.; Maillot, O.; Vieillard, J.; Feuilloley, M.G.J.; Orange, N.; Hancock, R.E.W.; Dufour, A.; et al. Transcription of the oprF gene of Pseudomonas aeruginosa is dependent mainly on the SigX sigma factor and is sucrose induced. J. Bacteriol. 2012, 194, 4301–4311. [Google Scholar] [CrossRef]
- Brinkman, F.S.; Schoofs, G.; Hancock, R.E.; De Mot, R. Influence of a putative ECF sigma factor on expression of the major outer membrane protein, OprF, in Pseudomonas aeruginosa and Pseudomonas fluorescens. J. Bacteriol. 1999, 181, 4746–4754. [Google Scholar] [CrossRef]
- Blanka, A.; Schulz, S.; Eckweiler, D.; Franke, R.; Bielecka, A.; Nicolai, T.; Casilag, F.; Düvel, J.; Abraham, W.-R.; Kaever, V.; et al. Identification of the alternative sigma factor SigX regulon and its implications for Pseudomonas aeruginosa pathogenicity. J. Bacteriol. 2014, 196, 345–356. [Google Scholar] [CrossRef] [PubMed]
- Bouffartigues, E.; Duchesne, R.; Bazire, A.; Simon, M.; Maillot, O.; Dufour, A.; Feuilloley, M.; Orange, N.; Chevalier, S. Sucrose favors Pseudomonas aeruginosa pellicle production through the extracytoplasmic function sigma factor SigX. FEMS Microbiol. Lett. 2014, 356, 193–200. [Google Scholar] [CrossRef]
- Bouffartigues, E.; Si Hadj Mohand, I.; Maillot, O.; Tortuel, D.; Omnes, J.; David, A.; Tahrioui, A.; Duchesne, R.; Azuama, C.O.; Nusser, M.; et al. The temperature-regulation of Pseudomonas aeruginosa cmaX-cfrX-cmpX operon reveals an intriguing molecular network involving the sigma factors AlgU and SigX. Front. Microbiol. 2020, 11, 579495. [Google Scholar] [CrossRef]
- Boechat, A.L.; Kaihami, G.H.; Politi, M.J.; Lepine, F.; Baldini, R.L. A novel role for an ECF sigma factor in fatty acid biosynthesis and membrane fluidity in Pseudomonas aeruginosa. PLoS ONE 2013, 8, e84775. [Google Scholar] [CrossRef] [PubMed]
- Fléchard, M.; Duchesne, R.; Tahrioui, A.; Bouffartigues, E.; Depayras, S.; Hardouin, J.; Lagy, C.; Maillot, O.; Tortuel, D.; Azuama, C.O.; et al. The absence of SigX results in impaired carbon metabolism and membrane fluidity in Pseudomonas aeruginosa. Sci. Rep. 2018, 8, 17212. [Google Scholar] [CrossRef]
- Duchesne, R.; Bouffartigues, E.; Oxaran, V.; Maillot, O.; Benard, M.; Feuilloley, M.G.J.; Orange, N.; Chevalier, S. A proteomic approach of SigX function in Pseudomonas aeruginosa outer membrane composition. J. Proteom. 2013, 94, 451–459. [Google Scholar] [CrossRef] [PubMed]
- Gicquel, G.; Bouffartigues, E.; Bains, M.; Oxaran, V.; Rosay, T.; Lesouhaitier, O.; Connil, N.; Bazire, A.; Maillot, O.; Bénard, M.; et al. The extra-cytoplasmic function sigma factor sigX modulates biofilm and virulence-related properties in Pseudomonas aeruginosa. PLoS ONE 2013, 8, e80407. [Google Scholar] [CrossRef]
- Hancock, R.E.; Carey, A.M. Outer membrane of Pseudomonas aeruginosa: Heat-2-mercaptoethanol-modifiable proteins. J. Bacteriol. 1979, 140, 902–910. [Google Scholar] [CrossRef] [PubMed]
- Lammens, E.; Ceyssens, P.J.; Voet, M.; Hertveldt, K.; Lavigne, R.; Volckaert, G. Representational Difference Analysis (RDA) of bacteriophage genomes. J. Microbiol. Methods 2009, 77, 207–213. [Google Scholar] [CrossRef] [PubMed]
- Kropinski, A.M.; Mazzocco, A.; Waddell, T.E.; Lingohr, E.; Johnson, R.P. Enumeration of bacteriophages by double agar overlay plaque assay. Methods Mol. Biol. 2009, 501, 69–76. [Google Scholar] [CrossRef] [PubMed]
- Rodrigues, S.; Paillard, C.; Dufour, A.; Bazire, A. Antibiofilm Activity of the Marine Bacterium Pseudoalteromonas sp. 3J6 Against Vibrio tapetis, the Causative Agent of Brown Ring Disease. Probiotics Antimicrob. Proteins 2015, 7, 45–51. [Google Scholar] [CrossRef]
- Pamp, S.J.; Sternberg, C.; Tolker-Nielsen, T. Insight into the microbial multicellular lifestyle via flow-cell technology and confocal microscopy. Cytometry A 2009, 75, 90–103. [Google Scholar] [CrossRef]
- Tolker-Nielsen, T.; Sternberg, C. Growing and analyzing biofilms in flow chambers. Curr. Protoc. Microbiol. 2011. [Google Scholar] [CrossRef] [PubMed]
- Heydorn, A.; Nielsen, A.T.; Hentzer, M.; Sternberg, C.; Givskov, M.; Ersboll, B.K.; Molin, S. Quantification of biofilm structures by the novel computer program COMSTAT. Microbiology 2000, 146, 2395–2407. [Google Scholar] [CrossRef] [PubMed]
- Vorregaard, M. Comstat2-a Modern 3D Image Analysis Environment for Biofilms. Ph.D. Thesis, Technical University of Denmark, Lyngby, Denmark, 2008. [Google Scholar]
- Strehmel, J.; Neidig, A.; Nusser, M.; Geffers, R.; Brenner-Weiss, G.; Overhage, J. Sensor kinase PA4398 modulates swarming motility and biofilm formation in Pseudomonas aeruginosa PA14. Appl. Environ. Microbiol. 2015, 81, 1274–1285. [Google Scholar] [CrossRef] [PubMed][Green Version]
- Baysse, C.; Cullinane, M.; Denervaud, V.; Burrowes, E.; Dow, J.M.; Morrissey, J.P.; Tam, L.; Trevors, J.T.; O’Gara, F. Modulation of quorum sensing in Pseudomonas aeruginosa through alteration of membrane properties. Microbiology 2005, 151, 2529–2542. [Google Scholar] [CrossRef] [PubMed]
- Bolger, A.M.; Lohse, M.; Usadel, B. Trimmomatic: A flexible trimmer for Illumina sequence data. Bioinformatics 2014, 30, 2114–2120. [Google Scholar] [CrossRef] [PubMed]
- Wingett, S.W.; Andrews, S. FastQ Screen: A tool for multi-genome mapping and quality control. F1000Res 2018, 7, 1338. [Google Scholar] [CrossRef]
- Wick, R.R.; Judd, L.M.; Gorrie, C.L.; Holt, K.E. Unicycler: Resolving bacterial genome assemblies from short and long sequencing reads. PLoS Comput. Biol. 2017, 13, e1005595. [Google Scholar] [CrossRef]
- Mikheenko, A.; Prjibelski, A.; Saveliev, V.; Antipov, D.; Gurevich, A. Versatile genome assembly evaluation with QUAST-LG. Bioinformatics 2018, 34, i142–i150. [Google Scholar] [CrossRef]
- Bushnell, B.; Rood, J.; Singer, E. BBMerge—Accurate paired shotgun read merging via overlap. PLoS ONE 2017, 12, e0185056. [Google Scholar] [CrossRef]
- Winsor, G.L.; Griffiths, E.J.; Lo, R.; Dhillon, B.K.; Shay, J.A.; Brinkman, F.S. Enhanced annotations and features for comparing thousands of Pseudomonas genomes in the Pseudomonas genome database. Nucleic Acids Res. 2016, 44, D646–D653. [Google Scholar] [CrossRef]
- Webb, J.S.; Thompson, L.S.; James, S.; Charlton, T.; Tolker-Nielsen, T.; Koch, B.; Givskov, M.; Kjelleberg, S. Cell death in Pseudomonas aeruginosa biofilm development. J. Bacteriol. 2003, 185, 4585–4592. [Google Scholar] [CrossRef]
- Köhler, T.; Donner, V.; Van Delden, C. Lipopolysaccharide as Shield and Receptor for R-Pyocin-Mediated Killing in Pseudomonas aeruginosa. J. Bacteriol. 2010, 192, 1921–1928. [Google Scholar] [CrossRef]
- Secor, P.R.; Michaels, L.A.; Smigiel, K.S.; Rohani, M.G.; Jennings, L.K.; Hisert, K.B.; Arrigoni, A.; Braun, K.R.; Birkland, T.P.; Lai, Y.; et al. Filamentous Bacteriophage Produced by Pseudomonas aeruginosa Alters the Inflammatory Response and Promotes Noninvasive Infection In Vivo. Infect. Immun. 2017, 85. [Google Scholar] [CrossRef]
- Kondo, F.; Satoh, S. Effects of subminimal inhibitory concentrations of beta-lactam antibiotics against R-plasmid-bearing bacteria. Chemotherapy 1995, 41, 125–133. [Google Scholar] [CrossRef]
- Justice, S.S.; Hunstad, D.A.; Cegelski, L.; Hultgren, S.J. Morphological plasticity as a bacterial survival strategy. Nat. Rev. Microbiol. 2008, 6, 162–168. [Google Scholar] [CrossRef] [PubMed]
- Bos, J.; Zhang, Q.; Vyawahare, S.; Rogers, E.; Rosenberg, S.M.; Austin, R.H. Emergence of antibiotic resistance from multinucleated bacterial filaments. Proc. Natl. Acad. Sci. USA 2015, 112, 178–183. [Google Scholar] [CrossRef]
- Breidenstein, E.B.; Janot, L.; Strehmel, J.; Fernandez, L.; Taylor, P.K.; Kukavica-Ibrulj, I.; Gellatly, S.L.; Levesque, R.C.; Overhage, J.; Hancock, R.E.W. The Lon protease is essential for full virulence in Pseudomonas aeruginosa. PLoS ONE 2012, 7, e49123. [Google Scholar] [CrossRef] [PubMed]
- Erickson, H.P.; Anderson, D.E.; Osawa, M. FtsZ in bacterial cytokinesis: Cytoskeleton and force generator all in one. Microbiol. Mol. Biol. Rev. 2010, 74, 504–528. [Google Scholar] [CrossRef] [PubMed]
- Colvin, K.M.; Irie, Y.; Tart, C.S.; Urbano, R.; Whitney, J.C.; Ryder, C.; Howell, P.L.; Wozniak, D.J.; Parsek, M.R. The Pel and Psl polysaccharides provide Pseudomonas aeruginosa structural redundancy within the biofilm matrix. Environ. Microbiol. 2012, 14, 1913–1928. [Google Scholar] [CrossRef] [PubMed]
- Yang, L.; Hengzhuang, W.; Wu, H.; Damkiaer, S.; Jochumsen, N.; Song, Z.; Givskov, M.C.; Høiby, N.; Molin, S. Polysaccharides serve as scaffold of biofilms formed by mucoid Pseudomonas aeruginosa. FEMS Immunol. Med. Microbiol. 2012, 65, 366–376. [Google Scholar] [CrossRef]
- Chew, S.C.; Kundukad, B.; Seviour, T.; van der Maarel, J.R.; Yang, L.; Rice, S.A.; Doyle, P.S.; Kjelleberg, S. Dynamic remodeling of microbial biofilms by functionally distinct exopolysaccharides. MBio 2014, 5, e01514–e01536. [Google Scholar] [CrossRef]
- Maunders, E.; Welch, M. Matrix exopolysaccharides; the sticky side of biofilm formation. FEMS Microbiol. Lett. 2017, 364. [Google Scholar] [CrossRef]
- Baynham, P.J.; Wozniak, D.J. Identification and characterization of AlgZ, an AlgT-dependent DNA-binding protein required for Pseudomonas aeruginosa algD transcription. Mol. Microbiol. 1996, 22, 97–108. [Google Scholar] [CrossRef] [PubMed]
- Baynham, P.J.; Brown, A.L.; Hall, L.L.; Wozniak, D.J. Pseudomonas aeruginosa AlgZ, a ribbon-helix-helix DNA-binding protein, is essential for alginate synthesis and algD transcriptional activation. Mol. Microbiol. 1999, 33, 1069–1080. [Google Scholar] [CrossRef]
- Jones, C.J.; Newsom, D.; Kelly, B.; Irie, Y.; Jennings, L.K.; Xu, B.; Limoli, D.H.; Harrison, J.J.; Parsek, M.R.; White, P.; et al. ChIP-Seq and RNA-Seq reveal an AmrZ-mediated mechanism for cyclic di-GMP synthesis and biofilm development by Pseudomonas aeruginosa. PLoS Pathog. 2014, 10, e1003984. [Google Scholar] [CrossRef]
- Xu, B.; Ju, Y.; Soukup, R.J.; Ramsey, D.M.; Fishel, R.; Wysocki, V.H.; Wozniak, D.J. The Pseudomonas aeruginosa AmrZ C-terminal domain mediates tetramerization and is required for its activator and repressor functions. Environ. Microbiol. Rep. 2016, 8, 85–90. [Google Scholar] [CrossRef]
- Xu, B.; Soukup, R.J.; Jones, C.J.; Fishel, R.; Wozniak, D.J. Pseudomonas aeruginosa AmrZ Binds to Four Sites in the algD Promoter, Inducing DNA-AmrZ Complex Formation and Transcriptional Activation. J. Bacteriol. 2016, 198, 2673–2681. [Google Scholar] [CrossRef] [PubMed]
- Jones, C.J.; Ryder, C.R.; Mann, E.E.; Wozniak, D.J. AmrZ modulates Pseudomonas aeruginosa biofilm architecture by directly repressing transcription of the psl operon. J. Bacteriol. 2013, 195, 1637–1644. [Google Scholar] [CrossRef]
- Baraquet, C.; Harwood, C.S. FleQ DNA Binding Consensus Sequence Revealed by Studies of FleQ-Dependent Regulation of Biofilm Gene Expression in Pseudomonas aeruginosa. J. Bacteriol. 2016, 198, 178–186. [Google Scholar] [CrossRef]
- Matsuyama, B.Y.; Krasteva, P.V.; Baraquet, C.; Harwood, C.S.; Sondermann, H.; Navarro, M.V. Mechanistic insights into c-di-GMP-dependent control of the biofilm regulator FleQ from Pseudomonas aeruginosa. Proc. Natl. Acad. Sci. USA 2016, 113, E209–E218. [Google Scholar] [CrossRef]
- Xu, A.; Zhang, M.; Du, W.; Wang, D.; Ma, L. A molecular mechanism for how sigma factor AlgT and transcriptional regulator AmrZ inhibit twitching motility in Pseudomonas aeruginosa. Environ. Microbiol. 2020. [Google Scholar] [CrossRef]
- Hickman, J.W.; Harwood, C.S. Identification of FleQ from Pseudomonas aeruginosa as a c-di-GMP-responsive transcription factor. Mol. Microbiol. 2008, 69, 376–389. [Google Scholar] [CrossRef] [PubMed]
- Romling, U.; Galperin, M.Y. Discovery of the Second Messenger Cyclic di-GMP. Methods Mol. Biol. 2017, 1657, 1–8. [Google Scholar] [CrossRef]
- Whitney, J.C.; Whitfield, G.B.; Marmont, L.S.; Yip, P.; Neculai, A.M.; Lobsanov, Y.D.; Robinson, H.; Ohman, D.E.; Howell, P.L. Dimeric c-di-GMP is required for post-translational regulation of alginate production in Pseudomonas aeruginosa. J. Biol. Chem. 2015, 290, 12451–12462. [Google Scholar] [CrossRef]
- Borlee, B.R.; Goldman, A.D.; Murakami, K.; Samudrala, R.; Wozniak, D.J.; Parsek, M.R. Pseudomonas aeruginosa uses a cyclic-di-GMP-regulated adhesin to reinforce the biofilm extracellular matrix. Mol. Microbiol. 2010, 75, 827–842. [Google Scholar] [CrossRef]
- Rybtke, M.T.; Borlee, B.R.; Murakami, K.; Irie, Y.; Hentzer, M.; Nielsen, T.E.; Givskov, M.; Parsek, M.R.; Tolker-Nielsen, T. Fluorescence-based reporter for gauging cyclic di-GMP levels in Pseudomonas aeruginosa. Appl. Environ. Microbiol. 2012, 78, 5060–5069. [Google Scholar] [CrossRef]
- Brissette, J.L.; Weiner, L.; Ripmaster, T.L.; Model, P. Characterization and sequence of the Escherichia coli stress-induced psp operon. J. Mol. Biol. 1991, 220, 35–48. [Google Scholar] [CrossRef]
- Andersen, C.L.; Holland, I.B.; Jacq, A. Verapamil, a Ca2+ channel inhibitor acts as a local anesthetic and induces the sigma E dependent extra-cytoplasmic stress response in E. coli. Biochim. Biophys. Acta Biomembr. 2006, 1758, 1587–1595. [Google Scholar] [CrossRef]
- Schulz, S.; Eckweiler, D.; Bielecka, A.; Nicolai, T.; Franke, R.; Dotsch, A.; Hornischer, K.; Bruchmann, S.; Düvel, J.; Häussler, S. Elucidation of sigma factor-associated networks in Pseudomonas aeruginosa reveals a modular architecture with limited and function-specific crosstalk. PLoS Pathog. 2015, 11, e1004744. [Google Scholar] [CrossRef]
- Kong, W.; Zhao, J.; Kang, H.; Zhu, M.; Zhou, T.; Deng, X.; Liang, H. ChIP-seq reveals the global regulator AlgR mediating cyclic di-GMP synthesis in Pseudomonas aeruginosa. Nucleic Acids Res. 2015, 43, 8268–8282. [Google Scholar] [CrossRef]
- Wachi, M.; Matsuhashi, M. Negative control of cell division by mreB, a gene that functions in determining the rod shape of Escherichia coli cells. J. Bacteriol. 1989, 171, 3123–3127. [Google Scholar] [CrossRef] [PubMed]
- Kruse, T.; Moller-Jensen, J.; Lobner-Olesen, A.; Gerdes, K. Dysfunctional MreB inhibits chromosome segregation in Escherichia coli. EMBO J. 2003, 22, 5283–5292. [Google Scholar] [CrossRef]
- Strahl, H.; Burmann, F.; Hamoen, L.W. The actin homologue MreB organizes the bacterial cell membrane. Nat. Commun. 2014, 5, 3442. [Google Scholar] [CrossRef] [PubMed]
- Chichili, G.R.; Rodgers, W. Cytoskeleton-membrane interactions in membrane raft structure. Cell. Mol. Life Sci. 2009, 66, 2319–2328. [Google Scholar] [CrossRef] [PubMed]
- Govindarajan, S.; Amster-Choder, O. The bacterial Sec system is required for the organization and function of the MreB cytoskeleton. PLoS Genet. 2017, 13, e1007017. [Google Scholar] [CrossRef]
- Bazire, A.; Dheilly, A.; Diab, F.; Morin, D.; Jebbar, M.; Haras, D.; Dufour, A. Osmotic stress and phosphate limitation alter production of cell-to-cell signal molecules and rhamnolipid biosurfactant by Pseudomonas aeruginosa. FEMS Microbiol. Lett. 2005, 253, 125–131. [Google Scholar] [CrossRef]

Publisher’s Note: MDPI stays neutral with regard to jurisdictional claims in published maps and institutional affiliations. |
© 2020 by the authors. Licensee MDPI, Basel, Switzerland. This article is an open access article distributed under the terms and conditions of the Creative Commons Attribution (CC BY) license (http://creativecommons.org/licenses/by/4.0/).
Share and Cite
Tortuel, D.; Tahrioui, A.; Rodrigues, S.; Cambronel, M.; Boukerb, A.M.; Maillot, O.; Verdon, J.; Bere, E.; Nusser, M.; Brenner-Weiss, G.; et al. Activation of the Cell Wall Stress Response in Pseudomonas aeruginosa Infected by a Pf4 Phage Variant. Microorganisms 2020, 8, 1700. https://doi.org/10.3390/microorganisms8111700
Tortuel D, Tahrioui A, Rodrigues S, Cambronel M, Boukerb AM, Maillot O, Verdon J, Bere E, Nusser M, Brenner-Weiss G, et al. Activation of the Cell Wall Stress Response in Pseudomonas aeruginosa Infected by a Pf4 Phage Variant. Microorganisms. 2020; 8(11):1700. https://doi.org/10.3390/microorganisms8111700
Chicago/Turabian StyleTortuel, Damien, Ali Tahrioui, Sophie Rodrigues, Mélyssa Cambronel, Amine M. Boukerb, Olivier Maillot, Julien Verdon, Emile Bere, Michael Nusser, Gerald Brenner-Weiss, and et al. 2020. "Activation of the Cell Wall Stress Response in Pseudomonas aeruginosa Infected by a Pf4 Phage Variant" Microorganisms 8, no. 11: 1700. https://doi.org/10.3390/microorganisms8111700
APA StyleTortuel, D., Tahrioui, A., Rodrigues, S., Cambronel, M., Boukerb, A. M., Maillot, O., Verdon, J., Bere, E., Nusser, M., Brenner-Weiss, G., David, A., Azuama, O. C., Feuilloley, M. G. J., Orange, N., Lesouhaitier, O., Cornelis, P., Chevalier, S., & Bouffartigues, E. (2020). Activation of the Cell Wall Stress Response in Pseudomonas aeruginosa Infected by a Pf4 Phage Variant. Microorganisms, 8(11), 1700. https://doi.org/10.3390/microorganisms8111700

